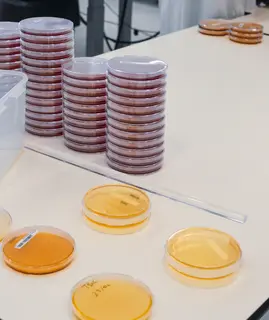
758737.jpg

Qualité

La rédaction de Process Alimentaire fait le point sur les principales évolutions qui vont marquer le secteur agroalimentaire en 2026.

C'est Noël avant l'heure à l'Afnor ! Disponible gratuitement en téléchargement, la nouvelle l’Afnor Spec relative à la food safety culture vient de paraître. Il s’agit d’un guide « à l’usage des dirigeants pour la mise en œuvre d’une culture positive de la sécurité des aliments ».

Certaines vaisselles biodégradables fabriquées à partir de blé peuvent transférer du gluten vers des aliments pourtant étiquetés sans gluten. Une étude récente montre que ce phénomène dépend du matériau, du type d’aliment, du temps de contact et de la température, avec des niveaux particulièrement…

Les dernières données européennes confirment que plusieurs résistances aux antimicrobiens continuent de progresser, avec des situations contrastées selon les pathogènes et les pays. En France, cette dynamique se traduit à la fois par un renforcement des actions en santé animale et par une montée en…

À partir de plus de 392 millions de résultats analytiques issus des contrôles officiels transmis à l’Efsa, une équipe de Wageningen Food Safety Research propose une lecture structurée des tendances de la surveillance des contaminants en Europe sur près de vingt-cinq ans. Cette analyse de grande…

La question des micro- et nanoplastiques progresse simultanément sur les terrains réglementaire et scientifique. Entre l'adoption d'un nouveau cadre européen sur les pertes de granulés plastiques et l'accumulation de données sur l'exposition alimentaire et les effets biologiques, le sujet s'impose…

La nouvelle version du guide de bonnes pratiques de fabrication (GMP) pour les encres, vernis et revêtements destinés aux matériaux au contact des aliments renforce l’analyse des risques, la gestion des substances non intentionnellement ajoutées et les exigences applicables aux encres en contact…

La version 2025 du Code des usages de la charcuterie, de la salaison et des conserves de viandes intègre des évolutions réglementaires structurantes, en particulier sur l’emploi des nitrites et nitrates, ainsi que plusieurs ajustements d’usages.

Entre un fabricant d’emballages et un acteur de l’agroalimentaire, les exigences en matière de sécurité des aliments sont différentes, car les dangers ne sont pas les mêmes. Comment dans ce cas auditer un fournisseur de manière adaptée et pertinente ? Illustration avec cinq points critiques, pour…

Le spécialiste de la qualité, sécurité et durabilité des aliments crée avec l’agence de conseil en communication institutionnelle une offre de préparation à la gestion de crise pour les entreprises du secteur agroalimentaire.

Certaines matrices végétales peuvent rendre non détectables, par les méthodes classiques de culture, des bactéries pourtant viables dans les aliments. Le projet Cultibac analyse ce phénomène chez les bactéries sporulées afin d’améliorer la fiabilité des analyses microbiologiques et l’évaluation du…

Des nanoplastiques de polystyrène, présents à de faibles niveaux et sans additifs chimiques, induisent des effets mesurables sur l’intestin et le foie chez la souris. Une étude montre que le régime alimentaire, en particulier de type occidental, module fortement ces réponses biologiques.

Lancé en 2024, le modèle d’analyse de données « Trusted Third Party » est destiné à renforcer la gestion des risques et la performance des filières agroalimentaires. Cette approche collaborative fournit aux industriels des informations consolidées et anonymisées pour améliorer leurs décisions et l…
Mérieux NutriSciences renforce ses capacités analytiques en France avec des investissements ciblés dans ses laboratoires de Merville (59) et de Saint-Herblain (44). Le groupe mise sur l’automatisation et le développement de méthodes sur mesure pour accompagner les industriels face aux évolutions du…

Le BRCGS, l’IFS et la fondation FSSC renforcent leurs exigences à destination des fabricants d’emballages. Le rattrapage des référentiels « food » est enclenché. Illustration avec les évolutions et annonces récentes.

Comment mener plus efficacement un audit de fournisseur d'emballages ? Dans le numéro de décembre 2025, Process Alimentaire fait le point sur les apports du réglementaire, des référentiels de sécurité des aliments et du recours à des prestataires externes.

L'entreprise bretonne Photon Lines propose désormais un logiciel d'analyse d'images hyperspectrales prêt à l'emploi, dopé à l'intelligence artificielle.

L’Anses publie les résultats d’une campagne nationale consacrée aux PFAS dans l’eau potable. La plupart des prélèvements analysés respectent les limites réglementaires, mais certaines substances émergentes comme le TFA sont détectées très fréquemment.

Le projet Emovol s’achève après cinq années de collaboration entre Inrae et Fleury Michon. Il a permis de concevoir un outil inédit, reposant sur des biomarqueurs microbiens, afin d’évaluer le potentiel de conservation de charcuteries cuites à base de volaille.

L’Eurobaromètre 2025 montre que les priorités et inquiétudes des citoyens évoluent. En France, les résultats confirment des spécificités marquées, notamment l’importance accordée à la provenance et une sensibilité croissante à certains risques émergents.

Le projet Prosper vise à mieux caractériser les risques microbiologiques associés aux farines de légumineuses et d’insectes. Conduit par l’Adria et le Lubem, il doit préciser la présence et le comportement des bactéries sporulées et des moisissures thermorésistantes dans ces matrices encore peu…

Ce 11 novembre la filiale du groupe Saur Nijhuis Saur Industries (NSI), spécialisée dans l’intégration de boucles de revalorisation de l’eau, a annoncé l’acquisition d’une participation majoritaire dans Coldep. Le partenariat vise à déployer à grande échelle la technologie brevetée par l’entreprise…

Conception hygiénique, intelligence artificielle, connectivité, nouvelles technologies de génération et d'analyse d'images. Les systèmes d'inspection évoluent pour gagner en précision, en rapidité et en capacité d'intégration dans les lignes. Sélection de nouveautés à découvrir dans les allées de…

Le projet collaboratif SporeFish a permis d’identifier l’origine des contaminations en spores thermophiles hautement thermorésistantes (HRS) dans les conserves poisson-crustacé et de mettre au point des outils de détection adaptés. Les travaux montrent que le renforcement de l’hygiène et la…

Entre 2011 et 2025, la souche Salmonella Strathcona ST2559 a été identifiée dans plusieurs dizaines de cas d'intoxication alimentaire dans au moins 17 pays européens. Parallèlement, des études parues récemment montrent la grande variabilité des sérovars de Salmonella spp. – tant dans les sources…

Trois études publiées en 2025 mettent en lumière la diversité des mycotoxines détectées dans les denrées alimentaires. Tandis que les aflatoxines restent les plus fréquemment signalées dans le RASFF, la citrinine et les énniatines apparaissent comme des contaminants émergents à suivre de près.

Bizerba a annoncé le 5 septembre 2025 le changement de nom de Bizerba Luceo en Bizerba Imaging Systems.

Les validations des méthodes d'amplification isotherme s'étendent sur une large gamme de matrices, pour des prises d'essais jusqu'à 375 g. La technologie se positionne aussi comme un appui au suivi de l'environnement, directement en atelier.

Analyses multiplexes, échantillons plus grands, protocoles harmonisés et plus ergonomiques accélèrent le travail au laboratoire. Évolution bonus, les méthodes moléculaires se doublent d’un accompagnement dans le suivi des contaminations.

Bio-Rad poursuit l’harmonisation de ses solutions pour la détection des pathogènes, avec une nouvelle génération de kits PCR en temps réel, EZ-Check, et l’extension des validations de ses milieux chromogéniques. En parallèle, la gamme XP-Design Assays ouvre la voie à une identification rapide des…

Les méthodes de détection de Salmonella spp. sont relativement matures. Peu d'évolutions sont à noter dans les technologies. Pour autant, la dynamique des méthodes moléculaires se confirme pour un suivi plus réactif et pertinent des contaminations.

Dans un rapport technique publié le 21 octobre 2025 l’Efsa (Autorité européenne de sécurité des aliments) a évalué le relargage de micro- et nanoplastiques par les matériaux au contact des aliments.

Une étude menée par Inrae, l’Inserm, l’Université Sorbonne Paris Nord et le Cnam, sur la cohorte NutriNet-Santé, montre que la consommation de produits d’origine végétale est associée à une meilleure santé cardiovasculaire à condition qu’ils soient peu transformés et de bonne qualité nutritionnelle.

Dans un rapport d'expertise publié en octobre 2025, l'Anses (Agence nationale de sécurité sanitaire de l'alimentation) dresse un état des lieux de la contamination des milieux par les composés per- et polyfluoroalkylés (PFAS) et propose une méthode pour hiérarchiser leur surveillance.

L'Institut de recherche sur la santé digestive (IRSD) a étudié, sur modèles cellulaires en trois dimensions, l'action de Salmonella typhimurium sur le fonctionnement de l'intestin.

Spécialisée dans les traitements vétérinaires personnalisés à base de phages, la jeune entreprise figure depuis mai 2025 dans la liste des établissements préparateurs autorisés en France. Elle s’apprête à accélérer son développement.

La Foundation FSSC a engagé le développement de la version 7 de son référentiel FSSC 22000.

La plateforme Aliment Emballage (PAE) de l’Ania a diffusé en septembre 2025 une nouvelle version de son modèle de déclaration de conformité relative aux matériaux et objets destinés à entrer en contact avec des denrées alimentaires.

Le dernier bulletin de Santé publique France met en évidence une augmentation inédite de la listériose depuis 2021. L’évolution concerne surtout les formes invasives, en lien avec le vieillissement de la population et l’augmentation des maladies chroniques.

Le réseau Actia Référentiels vient de publier le tome 2 de son guide dédié à la food safety culture. Après un premier opus consacré aux premiers pas dans la démarche, ce nouveau document regorge d’idées pour aller plus loin, en s’inspirant de retours d’expériences.

Financé par l’Office français de la biodiversité (OFB), le projet ReduSolBio vise à faire progresser les connaissances sur le sujet de la réduction du travail du sol en agriculture biologique, un enjeu agronomique et environnemental.

Greenpeace affirme, dans un rapport publié en septembre 2025, que « nos aliments sont contaminés par l’hexane », en citant des analyses montrant la présence de résidus dans des huiles, laits infantiles et viandes de volaille. Cette campagne ravive un débat ancien sur l’usage de ce solvant d…

Le spécialiste de la distribution de produits et de services pour l’environnement de travail a lancé une nouvelle offre pour optimiser les flux logistiques en matière d’essuie-mains, papier toilette et savon.

Le groupe Paredes Orapi a annoncé le 29 septembre la signature d'une alliance avec TopServ sur le marché allemand.

Développée avec des instituts techniques, des chercheurs, des chambres d’agriculture et des organisations non gouvernementales, la nouvelle plateforme de formation de Lidl propose plus de 450 ressources adaptées aux élevages avicoles, porcins et laitiers.

Entre 2004 et 2023, trois populations principales de Bacillus cereus sensu lato ont été identifiées dans les Tiac en France, chacune liée à des catégories d'aliments spécifiques. Ces populations présentent aussi des profils distincts de résistance aux antibiotiques et des proximités génétiques avec…

Une enquête menée par le SNV (Service national des enquêtes) et la DGCCRRF (Direction générale de la concurrence, de la consommation et de la répression des fraudes) a mis en évidence des irrégularités dans la gestion de la crise à l'oxyde d'éthylène par Cargill en 2021 et 2022. L'entreprise a…

Sur la base des données du RASFF entre 2011 et 2024, une étude récente identifie plusieurs couples herbe/épice – danger à haut risque.


